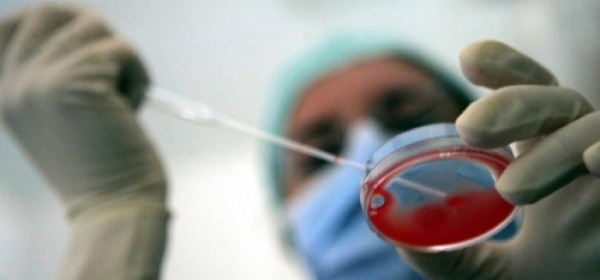

Archivio Storico
Seleziona l'anno
Seleziona il mese
Notizie di Lunedì, 19 Febbraio 2018
Anatra zoppa al comune di Avezzano, Consiglio di Stato conferma sentenza Tar
L'Aquila - Il Consiglio di Stato ha confermato la sentenza del Tar dell'Aquila ribaltando definitivamente i...
pubblicato il 19/02/2018 13:43
Morto il regista Tonino Zangardi Tra i suoi film Allullo Drom, Sandrine nella pioggia e Nuvolari
Roma - E' morto il regista Tonino Zangardi, nato a Roma il 23 aprile del 1957, l'autore era malato da...
pubblicato il 19/02/2018 12:52
All’Arma dei Carabinieri la cittadinanza onoraria del Comune dell'Aquila
L'Aquila - Si terrà martedì 20 febbraio, alle 19.30, nella basilica di Santa Maria di Collemaggio, il...
pubblicato il 19/02/2018 12:43
Trasporti, contratto di servizio Ama-Comune dell'Aquila prorogato alla fine del 2027
L'Aquila - La delibera che individua la nuova scadenza al 31 dicembre 2027 del contratto di servizio di Ama...
pubblicato il 19/02/2018 12:40
Musica per superare barriere autismo L'Aquila, sul palco NapulAmmore e Federico Santangelo
L'Aquila - Auditorium Renzo Piano gremito, a L'Aquila, per il concerto promosso da Autismo Abruzzo Onlus con...
pubblicato il 19/02/2018 12:38
Brasile, sepolta viva, sopravvive nella tomba per 11 giorni
Roma - Una donna sarebbe stata sepolta viva per errore e, dopo essersi risvegliata dentro la bara,...
pubblicato il 19/02/2018 12:33
Usa, creato embrione ibrido pecora-uomo E' secondo dopo maiale-uomo
Roma - Per la prima volta è stato creato in laboratorio un embrione ibrido uomo-pecora, in cui una...
pubblicato il 19/02/2018 09:58
GdF L'Aquila, pubblicato bando di concorso per arruolamento 61 allievi ufficiali
L'Aquila - Sulla Gazzetta Ufficiale della Repubblica Italiana - 4a Serie Speciale – nr. 13 del 13 febbraio...
pubblicato il 19/02/2018 09:52
47mld di euro le imposte e tasse locali, ogni famiglia ha pagato nel 2017 oltre 2000 euro
Roma - Ammontano a 47 miliardi di euro le imposte e tasse locali, regionali e comunali, pagate dai...
pubblicato il 19/02/2018 09:46
Valanga in Alto Adige, travolti 20 alpinisti tutti salvi
Bolzano - Una valanga in Alto Adige, a Racines, ha travolto un gruppo di venti scialpinisti austriaci di...
pubblicato il 19/02/2018 09:43
Operazione anti 'Ndrangheta, la Dia effettua 27 fermi e sequestra beni per 100 mln di euro
Sono 27 le persone destinatarie del provvedimento di fermo emesso dalla Dda di Reggio Calabria...
pubblicato il 19/02/2018 09:37
Orrore nel palermitano facevano prostituire figlia di 9 anni, agli arresti genitori e clienti
Palermo - Facevano prostituire la figlia di nove anni: con l'accusa di violenza sessuale e sfruttamento...
pubblicato il 19/02/2018 09:33
Persiste ondata di piogge al Centrosud, nevicate in bassa quota al centro
Roma - SITUAZIONE: il Paese si appresta ad una settimana invernale, infatti una circolazione di bassa...
pubblicato il 19/02/2018 09:29
Colta da infarto cade nel camino acceso, morta 92enne a Teramo
Teramo - Tragedia in un'abitazione nella frazione di Villa Stanghieri a Teramo, nella tarda mattinata di...
pubblicato il 19/02/2018 09:26
Iran, aereo precipitato in Iran nessun superstite, a bordo erano 60 passeggeri e 6 membri equipaggio
Roma - Sarebbero tutti morti i 66 passeggeri a bordo dell'aereo che si è schiantato contro il monte...
pubblicato il 19/02/2018 09:23
febbraio 2018